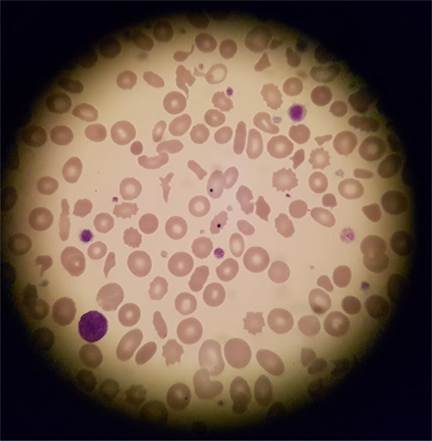
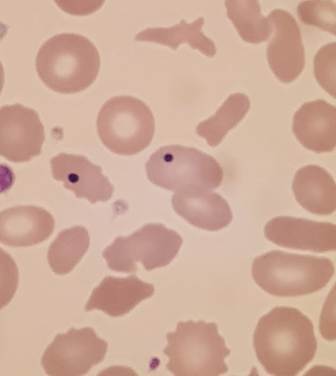
A close-up of a microscope

Description automatically generated
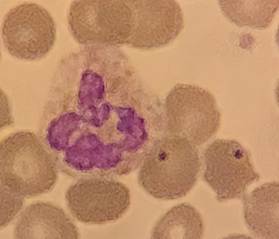

Howell-Jolly Bodies
Created 17 January 2011.
Updated 16 January 2021 (incorporating
Google Document of 6 March 2018 & updated to new format)
Updated 16 May 2024 (added a new
case)
Updated 7 January 2026 (updated to
new format)
|
Meanwhile… down the microscope Here’s something
I saw down the microscope only the other day. Note the bizarre red cells
(marked anisopoikilocytosis with macrocytes), the
giant platelets, what *are* those white cells?.... And look at those red cells in the middle of the field |
|
Howell-Jolly bodies
are black circular inclusions seen in red cells (when using standard Lieshman staining). Named after William Henry Howell and Justin Marie Jolly they are nuclear
remnants.
During normal erythropoesis (in the bone marrow) the red cell
nucleus is expelled at the late erythroblast stage. Normally the nuclear
expulsion is total, but in some cases a small portion of DNA remains. These are
the Howell-Jolly bodies, and are then removed as the
red cells pass through the spleen. Their presence in peripheral blood (in
any significant number) is indicative of splenic inadequacy;
either a damaged or absent spleen.
|
They can be either primary (i.e.
post splenectomy or traumatic splenic damage) or secondary to a range of
conditions. Interestingly the absence of
Howell-Jolly bodies in health seems to be peculiar to humans. They are
present (albeit in low numbers) in many other mammalian species; especially noticeable in cats and horses. |
|
|
|
Here’s one I saw in early 2024… with MCV 135 and folate <4.5 there’s
Howell-Jolly bodies and right shifted (hypersegmented)
neutrophils too. |
|
Some More Expert Opinion…
https://www.gpnotebook.co.uk/simplepage.cfm?ID=-1825243106
http://www.eclinpath.com/hematology/morphologic-features/red-blood-cells/quick-guide/